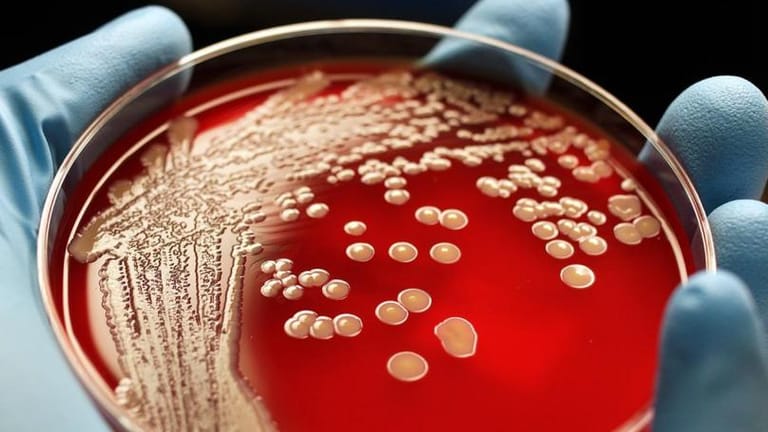

أثارت وفاة طفل تركي يبلغ من العمر 3 سنوات، الكثير من الجدل في تركيا بعد تضارب في التقرير الطبي للمشفى والطبيب الذي تلقى لديه العلاج حول إصابته بـ Strep A وهي عدوى بكتيرية تصيب الحلق والجلد وتسبب غالباً حمى وألما بالحلق، فهل وصلت بالفعل هذه البكتيريا التي تجدد انتشارها في عدد من دول العالم أخيراً إلى تركيا أيضاً؟
وفق وسائل إعلام تركية محلّية، يدعى الطفل آراس سونماز وقد فارق الحياة في العاصمة أنقرة قبل نحو أسبوعين بعدما أصيب بـ Strep A وفق ما أكد والده لوسائل الإعلام، إلا أن المستشفى الذي نُقِل إليه لم يقرّ بذلك، فقد كُتِب في التقرير الطبي أن "حالة الوفاة طبيعية ويعود سببها لانتشار فيروس مجهول الهوية في البلاد"، رغم أن الطبيب الذي تلقى الطفل الصغير العلاج لديه كان قد كشف لوالده أن نجله أصيب بالفعل بعدوى بكتيرية، الأمر الذي تسبب بكثير من الجدل في تركيا.
وتعليقاً على التضارب المتواصل حول أسباب وفاة الطفل، أشار مسؤول تركي بارز في القطاع الطبي إلى أن "بكتيريا Strep A عاودت الانتشار أخيراً في عدد من دول العالم مثلما حصل في بريطانيا، وذلك بعد سنوات من غيابها، وهو ما أثار القلق لدى العديد من تلك الدول، لكن الأمر مختلف بالنسبة إلى تركيا".
وفق وسائل إعلام تركية محلّية، يدعى الطفل آراس سونماز وقد فارق الحياة في العاصمة أنقرة قبل نحو أسبوعين بعدما أصيب بـ Strep A وفق ما أكد والده لوسائل الإعلام، إلا أن المستشفى الذي نُقِل إليه لم يقرّ بذلك، فقد كُتِب في التقرير الطبي أن "حالة الوفاة طبيعية ويعود سببها لانتشار فيروس مجهول الهوية في البلاد"، رغم أن الطبيب الذي تلقى الطفل الصغير العلاج لديه كان قد كشف لوالده أن نجله أصيب بالفعل بعدوى بكتيرية، الأمر الذي تسبب بكثير من الجدل في تركيا.
وتعليقاً على التضارب المتواصل حول أسباب وفاة الطفل، أشار مسؤول تركي بارز في القطاع الطبي إلى أن "بكتيريا Strep A عاودت الانتشار أخيراً في عدد من دول العالم مثلما حصل في بريطانيا، وذلك بعد سنوات من غيابها، وهو ما أثار القلق لدى العديد من تلك الدول، لكن الأمر مختلف بالنسبة إلى تركيا".